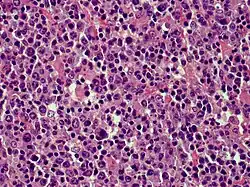
Cutaneous diffuse large B-cell lymphoma (DLBCL)

Cutaneous B-cell lymphoma
| Cutaneous B-cell lymphoma | |
|---|---|
![]() | |
| Cutaneous diffuse large B-cell lymphoma | |
| Specialty | Dermatology/Oncology |
Cutaneous B-cell lymphomas (CBCL), more recently termed Primary cutaneous B-cell lymphomas and lymphoproliferative disorders (PCBCLPD), are a group of disorders that typically present as skin lesions consisting of proliferating B-cells. B-cells are a type of lymphocyte involved in regulating immune responses. (The "primary" used to designate cutaneous lymphomas indicates that the lymphoma was first diagnosed as limited to the skin and there was no evidence of spread to extracutaneous tissues for 6 months after the diagnosis was first made.[1]) Since its original definition in 1997, CBCL has been considered to have a varying number of subtypes by the European Organisation for Research and Treatment of Cancer, i.e., EORTC, and World Health Organization, i.e., WHO.[2] The latest revised classification of CBCL, which was published by EORTC in 2022, lists the following three main subtypes of CBCL (now termed PCBCLPD):[3]
- Primary cutaneous marginal zone lymphoproliferative disorder (formerly termed primary cutaneous marginal zone lymphoma)
- Primary cutaneous follicular lymphoma (also termed primary cutaneous follicular center lymphoma or primary cutaneous follicular centre lymphoma)
- Primary cutaneous diffuse large B-cell lymphoma, leg type
Because recent studies had shown that primary cutaneous marginal zone lymphoma, which was formerly classified as a subtype of the MALT lymphomas: a) has a distinct microscopic histology and gene expression profile; b) spreads to extracutaneous tissue in only 4 to 8.5% of cases; c) has a 5 year disease-specific survival in excess of 99% even in patients not receiving aggressive therapy; and d) has pathological findings that overlap the benign cutaneous disorders termed cutaneous lymphoid hyperplasia. Consequently, EORTC, 2022, renamed primary cutaneous marginal zone lymphoma as primary cutaneous marginal zone lymphoproliferative disorder.[3] Primary cutaneous follicle center lymphoma is also an indolent lymphoma.[4] The majority of patients achieve complete remissions following surgery and/or radiation therapy. Its spread to extracutaneous tissues is rare (10%) and has a 5-year overall survival and disease-specific survival of 87% and 95%, respectively.[3] Primary cutaneous diffuse large B-cell lymphoma, leg type is an aggressive B-cell lymphoma that is often resistant to therapy and carries a poor prognosis,[5] i.e., they have a 5-year disease-specific survival rate of 43% or 70% depending on whether their cancer cells have or do not have, respectively, inactivating mutations in both of their CDKN2A genes.[6]
References
- ^ Magro CM, Porcu P, Ahmad N, Klinger D, Crowson AN, Nuovo G (September 2004). "Cutaneous immunocytoma: a clinical, histologic, and phenotypic study of 11 cases". Applied Immunohistochemistry & Molecular Morphology. 12 (3): 216–24. doi:10.1097/00129039-200409000-00006. PMID 15551734.
- ^ Willemze R, Cerroni L, Kempf W, Berti E, Facchetti F, Swerdlow SH, Jaffe ES (April 2019). "The 2018 update of the WHO-EORTC classification for primary cutaneous lymphomas". Blood. 133 (16): 1703–1714. doi:10.1182/blood-2018-11-881268. PMC 6473500. PMID 30635287.
- ^ a b c Goodlad JR, Cerroni L, Swerdlow SH (January 2023). "Recent advances in cutaneous lymphoma-implications for current and future classifications". Virchows Archiv. 482 (1): 281–298. doi:10.1007/s00428-022-03421-5. PMC 9852132. PMID 36278991.
- ^ Medeiros LJ, Chadburn A, Natkunam Y, Naresh KN (April 2024). "Fifth Edition of the World Health Classification of Tumors of the Hematopoietic and Lymphoid Tissues: B-cell Neoplasms". Modern Pathology. 37 (4): 100441. doi:10.1016/j.modpat.2024.100441. PMID 38309432.
- ^ Trethewey CS, Walter HS, Alqahtani AN, Schmid R, Guttery DS, Griffin Y, Ahearne MJ, Saldanha GS, Jayne SP, Dyer MJ (March 2022). "Limitations of Monitoring Disease Progression Using Circulating Tumor DNA in Lymphoma: An Example From Primary Cutaneous DLBCL Leg-type". HemaSphere. 6 (3): e690. doi:10.1097/HS9.0000000000000690. PMC 8893288. PMID 35261967.
- ^ Senff NJ, Zoutman WH, Vermeer MH, Assaf C, Berti E, Cerroni L, Espinet B, de Misa Cabrera RF, Geerts ML, Kempf W, Mitchell TJ, Paulli M, Petrella T, Pimpinelli N, Santucci M, Whittaker SJ, Willemze R, Tensen CP (May 2009). "Fine-mapping chromosomal loss at 9p21: correlation with prognosis in primary cutaneous diffuse large B-cell lymphoma, leg type". The Journal of Investigative Dermatology. 129 (5): 1149–55. doi:10.1038/jid.2008.357. PMID 19020554.